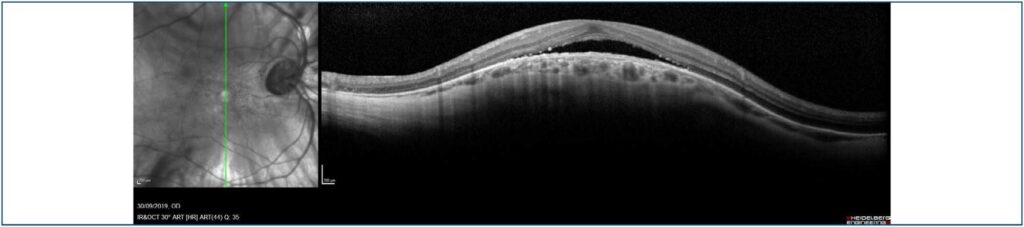

Rev Bras Oftalmol.2022;81:e0029
Descolamento seroso da retina neurossensorial associado à mácula dome-shaped: relato de dois casos
DOI: 10.37039/1982.8551.20220029
RESUMO
A mácula dome-shaped consiste na elevação convexa da região macular, encontrada principalmente em pacientes com alta miopia. O significado clínico e a correlação com outras patologias oculares ainda são incertos. Este artigo tem como objetivo descrever dois casos de mácula dome-shaped com acúmulo de fluido sub-retiniano em olhos alto míopes. Trata-se de pacientes com baixa acuidade visual, fundus miopicos e nítida elevação em forma de cúpula na área macular vista na tomografia de coerência óptica. A mácula dome-shaped pode cursar com descolamento seroso da retina neurossensorial envolvendo a fóvea, levando à baixa acuidade visual. Sua patogênese ainda não é bem estabelecida. De acordo com a tomografia de coerência óptica, a mácula dome-shaped pode ser classificada em três tipos morfológicos, sendo, nesses dois casos, demonstrada a disposição oval horizontalizada. Interessante ressaltar que o diagnóstico de mácula dome-shaped deve ser considerado em pacientes alto míopes, especialmente quando há queixa de baixa acuidade visual, que pode estar relacionada à presença de fluido sub-retiniano. Como o exame clínico não permite o diagnóstico adequado da mácula em cúpula, a realização da tomografia de coerência óptica com cortes verticais e horizontais é fundamental na suspeita de mácula dome-shaped.
Palavras-chave: Descolamento retiniano; Mácula lútea; Miopia; Tomografia de coerência óptica